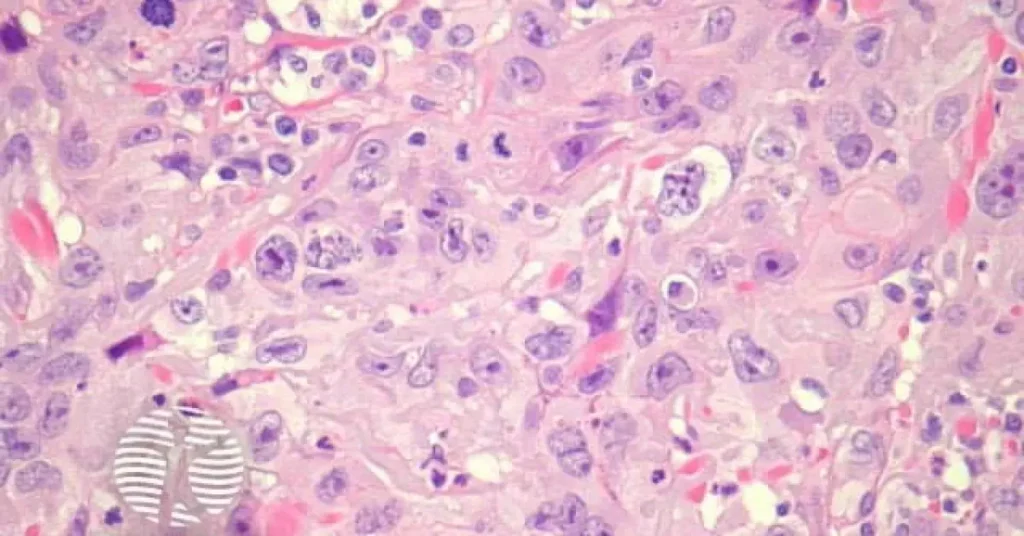

Das epitheloides Angiosarkom ist eine extrem seltene, aber hochaggressive Form des Weichteilsarkoms, die aus den Endothelzellen der Blutgefäße entsteht. Obwohl diese Krebsart nur einen sehr kleinen Anteil aller Tumorerkrankungen ausmacht, zeichnet sie sich durch ein schnelles Wachstum, frühe Metastasierung und eine oft schwierige Diagnose aus.
Besonders gefährlich ist, dass ein epitheloides Angiosarkom häufig unspezifische Symptome verursacht, die leicht mit harmlosen Erkrankungen verwechselt werden können.
Ein epitheloides Angiosarkom kann nahezu jeden Bereich des Körpers betreffen – einschließlich Haut, Weichteile, Leber oder Lunge. Die komplexe Struktur der tumorösen Endothelzellen erschwert die Behandlung und erfordert eine interdisziplinäre Betreuung durch Onkologen, Pathologen und Chirurgen.
Da die Erkrankung aggressiv verläuft, spielt eine möglichst frühe Erkennung eine entscheidende Rolle. Moderne diagnostische Methoden wie immunhistochemische Tests haben die Diagnose eines epitheloiden Angiosarkoms in den letzten Jahren verbessert, doch bleibt die Erkrankung weiterhin eine onkologische Herausforderung.
Was ist ein epitheloides Angiosarkom?
Das epitheloide Angiosarkom ist eine seltene Unterform der Angiosarkome. Charakteristisch sind tumorerzeugende Endothelzellen, die sich epithelialähnlich verhalten – daher der Name „epitheloid“.
Zu den wichtigsten Merkmalen zählen:
- Sehr hohe Wachstumsrate
- Frühe Ausbreitung über Blutbahn oder Lymphsystem
- Unspezifische Symptome
- Schwierige histologische Diagnose
Oft wird die Erkrankung erst in einem fortgeschrittenen Stadium entdeckt.
Das epitheloide Angiosarkom tritt häufig in verschiedenen Organen wie Haut, Weichteilen, Leber oder Lunge auf und stellt eine diagnostische Herausforderung dar. Die Therapieansätze umfassen in der Regel eine Kombination aus operativen Eingriffen, Strahlentherapie und Chemotherapie, wobei die Prognose durch die frühe Erkennung und das Stadium der Erkrankung maßgeblich beeinflusst wird.
Ursachen & Risikofaktoren
Die genauen Ursachen eines epitheloiden Angiosarkoms sind bis heute nicht vollständig geklärt. Jedoch gibt es einige bekannte Risikofaktoren:
- Strahlenexposition nach früheren Krebsbehandlungen
- Chronische Lymphödeme
- Chemische Belastungen durch bestimmte Karzinogene
- Genetische Mutationen, die das Zellwachstum beeinflussen
Dennoch können viele Fälle nicht eindeutig einem Risikofaktor zugeordnet werden.
Ein epitheloides Angiosarkom zeigt häufig ein aggressives Wachstumsverhalten und kann sich sowohl lokal ausbreiten als auch Metastasen in entfernten Organen bilden. Typische Symptome wie Schmerzen, Schwellungen oder Verfärbungen an der betroffenen Stelle treten oft erst in fortgeschrittenen Stadien auf, was die frühzeitige Diagnose erschwert.

Symptome
Die Symptome hängen stark vom betroffenen Organ ab, beinhalten aber häufig:
- Schmerzen oder Schwellungen
- Hautveränderungen oder Knoten
- Atemnot (bei Lungenbefall)
- Ungewollter Gewichtsverlust
- Müdigkeit und allgemeine Schwäche
Je früher Symptome erkannt werden, desto besser sind die Behandlungschancen.
Zusätzlich können unspezifische Beschwerden wie Fieber, nächtliches Schwitzen oder ein allgemeines Krankheitsgefühl auftreten, was die Diagnosestellung weiter erschwert, da diese Symptome auch bei vielen anderen, weniger ernsthaften Erkrankungen vorkommen können.
Diagnose
Da die Erkrankung selten vorkommt, wird sie häufig erst spät diagnostiziert. Typische diagnostische Schritte sind:
- Bildgebende Verfahren (CT, MRT, PET-Scan)
- Biopsie und histopathologische Untersuchung
- Immunhistochemische Marker (z. B. CD31, ERG, FLI-1)
Eine präzise Diagnose ist entscheidend, um die richtige Therapie zu wählen.
Die Prognose der Erkrankung hängt maßgeblich von dem Zeitpunkt der Diagnosestellung und dem Fortschreiten der Krankheit ab. Frühzeitige Erkennung und Therapie können die Überlebensrate sowie die Lebensqualität der Betroffenen verbessern, während fortgeschrittene Stadien oft eine eingeschränkte Prognose mit sich bringen.
Behandlungsmethoden
Die Behandlung hängt vom Stadium und der Lage des Tumors ab. Die wichtigsten Therapien umfassen:
Operationen, Bestrahlung und Chemotherapie, die je nach Krankheitsverlauf einzeln oder in Kombination angewendet werden können. Ziel ist es, den Tumor vollständig zu entfernen oder seine Ausbreitung zu verhindern, um die Lebensqualität der Patientinnen und Patienten möglichst lange zu erhalten.
1. Chirurgische Entfernung
Wenn möglich, wird der Tumor komplett entfernt. Eine vollständige Resektion bietet die besten Überlebenschancen.
Die chirurgische Entfernung ist jedoch nicht immer möglich, insbesondere wenn der Tumor schwer zugänglich ist oder bereits in umliegendes Gewebe oder entfernte Organe metastasiert hat. In solchen Fällen wird oft eine Kombination aus verschiedenen Therapien eingesetzt, um das Tumorwachstum zu kontrollieren und die Symptome zu lindern.
2. Strahlentherapie
Wird häufig ergänzend eingesetzt, um verbliebene Tumorzellen abzutöten.
Die Strahlentherapie kann sowohl kurativ als auch palliativ angewendet werden, abhängig vom Stadium der Erkrankung und dem allgemeinen Gesundheitszustand des Patienten. Sie zielt darauf ab, das Tumorvolumen zu reduzieren, Schmerzen zu lindern und die Lebensqualität zu verbessern, indem hochenergetische Strahlung eingesetzt wird, um die DNA der Krebszellen zu schädigen und deren Vermehrung zu verhindern.
3. Chemotherapie
Kombinationen aus Anthrazyklinen, Paclitaxel oder Ifosfamid werden eingesetzt.
Die Chemotherapie kann sowohl als alleinige Behandlung als auch in Kombination mit anderen Therapien wie der Strahlentherapie oder der Operation eingesetzt werden. Abhängig von der Art und dem Fortschreiten des Tumors wird die Dosierung und Kombination der Medikamente angepasst, um eine maximale Wirksamkeit zu erzielen und Nebenwirkungen so gering wie möglich zu halten.
4. Zielgerichtete Therapien
Moderne, teilweise experimentelle Ansätze wie Anti-VEGF-Therapien zeigen bei einigen Patienten positive Effekte.
Die zielgerichteten Therapien basieren auf spezifischen molekularen Mechanismen, die das Tumorwachstum fördern, und versuchen diese gezielt zu blockieren. Sie bieten insbesondere bei Patienten mit bestimmten genetischen Mutationen oder Biomarkern eine vielversprechende Behandlungsoption und eröffnen neue Möglichkeiten in der personalisierten Medizin.
Epitheloides Angiosarkom Lunge
Ein epitheloides Angiosarkom der Lunge ist besonders gefährlich, da die Lunge ein lebenswichtiges Organ mit starkem Gefäßnetz ist. Tumorzellen breiten sich schnell aus, und Symptome wie Atemnot, Brustschmerzen, Husten oder blutiger Auswurf treten häufig erst spät auf.
Die Diagnose erfolgt meist über CT-Scans und eine Biopsie. Aufgrund der Lage ist eine vollständige Operation oft schwierig, daher kommen häufig Strahlen- und Chemotherapie zum Einsatz.
Für weitere spannende Neuigkeiten und Updates besuchen Sie weiterhin Newswerder.de